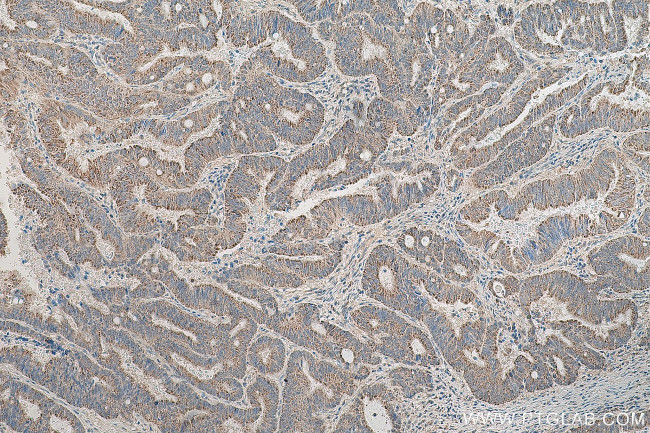
MFN2 Antibody in Immunohistochemistry (Paraffin) (IHC (P))
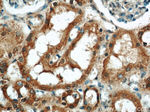
MFN2 Antibody in Immunohistochemistry (Paraffin) (IHC (P))

Search
Proteintech
MFN2 Polyclonal Antibody
{{$productOrderCtrl.translations['antibody.pdp.commerceCard.promotion.promotions']}}
{{$productOrderCtrl.translations['antibody.pdp.commerceCard.promotion.viewpromo']}}
{{$productOrderCtrl.translations['antibody.pdp.commerceCard.promotion.promocode']}}: {{promo.promoCode}} {{promo.promoTitle}} {{promo.promoDescription}}. {{$productOrderCtrl.translations['antibody.pdp.commerceCard.promotion.learnmore']}}
产品信息
12186-1-AP
种属反应
已发表种属
宿主/亚型
分类
类型
抗原
偶联物
形式
浓度
规格
纯化类型
保存液
内含物
保存条件
运输条件
产品详细信息
Immunogen sequence: SLLFSRCNS IVTVKKNKRH MAEVNASPLK HFVTAKKKIN GIFEQLGAYI QESATFLEDT YRNAELDPVT TEEQVLDVKG YLSKVRGISE VLARRHMKVA FFGRTSNGKS TVINAMLWDK VLPSGIGHTT NCFLRVEGTD GHEAFLLTEG SEEKRSAKTV NQLAHALHQD KQLHAGSLVS VMWPNSKCPL LKDDLVLMDS PGIDVTTELD SWIDKFCLDA DVFVLVANSE STLMQTEKHF FHKVSERLSR PNIFILNNRW DASASEPEYM EEVRRQHMER CTSFLVDELG VVDRSQAGDR IFFVSAKEVL NARIQKAQGM PEGGGALAEG FQVRMFEFQN FERRFEECIS QSA (2-353 aa encoded by BC017061)
靶标信息
This gene encodes a mitochondrial membrane protein that participates in mitochondrial fusion and contributes to the maintenance and operation of the mitochondrial network. This protein is involved in the regulation of vascular smooth muscle cell proliferation, and it may play a role in the pathophysiology of obesity. Mutations in this gene cause Charcot-Marie-Tooth disease type 2A2, and hereditary motor and sensory neuropathy VI, which are both disorders of the peripheral nervous system. Defects in this gene have also been associated with early-onset stroke. Two transcript variants encoding the same protein have been identified.
仅用于科研。不用于诊断过程。未经明确授权不得转售。
生物信息学
蛋白别名: CPRP 1; HSG protein; hyperplasia suppressor; hypertension related protein 1; hypertension-related protein; Hypertension-related protein 1; MARF; GTP-binding transmembrane protein; MFN 2; Mitochondrial assembly regulatory factor; mitochondrial transmembrane GTPase FZO1A; Mitofusin-2; Mitofusin2; Transmembrane GTPase MFN2; unnamed protein product
基因别名: CMT2A; CMT2A2; CMT2A2A; CMT2A2B; CPRP1; D630023P19Rik; Fzo; HMSN6A; HSG; KIAA0214; MARF; MFN2; MSL
UniProt ID: (Human) O95140, (Mouse) Q80U63
Entrez Gene ID: (Human) 9927, (Mouse) 170731, (Rat) 64476